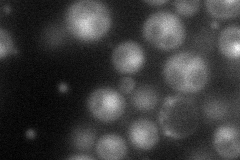
YDR489W
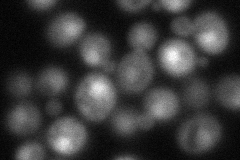
YDR489W
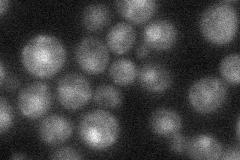
YDR489W
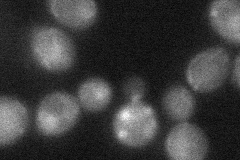
YDR489W
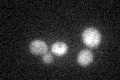
YDR489W

View description
Subunit of the GINS complex (Sld5p, Psf1p, Psf2p, Psf3p), which is localized to DNA replication origins and implicated in assembly of the DNA replication machinery
Localization:
Intensity:
Fold change:
Significance:
-
C’ GFP library in SD

cytosol25.25 -
N' NOP1pr-GFP in SD
cytosol,nucleus66.5099 -
N' TEF2pr-mCherry in SD
nucleus51.9738 -
N' NATIVEpr-GFP in SD
nucleus27.7704 -
N' TEF2pr-VC and Cyto-VN in SD
cytosol32.7476 -
C’ GFP library in SD+DTT

cytosolN/AN/ANo -
C’ GFP library in SD+H2O2

cytosolN/AN/ANo -
C’ GFP library in Starvation Media
cytosolN/AN/AYes -
C’ GFP library on the background of Pup2-DaMP

cytosol -
C’ GFP library on the background of CCT mutant

cytosolN/AN/ANo
